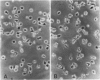

Abstract
Retinol (vitamin A) and retinoic acid, at concentrations in the physiological range, were found to exert potent regulatory effects on the function of macrophages; suppressing the expression of Fc receptors and the subsequent phagocytosis of opsonized cells but enhancing production of the tumouricidal enzyme arginase. Another dietary essential lipid-soluble molecule, arachidonic acid, from which a number of active molecules known to regulate cellular function are derived, had no effect on macrophage receptor expression or phagocytosis.
Full text
PDF





Images in this article
Selected References
These references are in PubMed. This may not be the complete list of references from this article.
- Cohen B. E., Elin R. J. Vitamin A-induced nonspecific resistance to infection. J Infect Dis. 1974 May;129(5):597–600. doi: 10.1093/infdis/129.5.597. [DOI] [PubMed] [Google Scholar]
- Currie G. A. Activated macrophages kill tumour cells by releasing arginase. Nature. 1978 Jun 29;273(5665):758–759. doi: 10.1038/273758a0. [DOI] [PubMed] [Google Scholar]
- Currie G. A., Basham C. Differential arginine dependence and the selective cytotoxic effects of activated macrophages for malignant cells in vitro. Br J Cancer. 1978 Dec;38(6):653–659. doi: 10.1038/bjc.1978.270. [DOI] [PMC free article] [PubMed] [Google Scholar]
- Dennert G., Crowley C., Kouba J., Lotan R. Retinoic acid stimulation of the induction of mouse killer T-cells in allogeneic and syngeneic systems. J Natl Cancer Inst. 1979 Jan;62(1):89–94. [PubMed] [Google Scholar]
- Dresser D. W. Adjuvanticity of vitamin A. Nature. 1968 Feb 10;217(5128):527–529. doi: 10.1038/217527a0. [DOI] [PubMed] [Google Scholar]
- Floersheim G. L., Bollag W. Accelerated rejection of skin homografts by vitamin A acid. Transplantation. 1972 Nov;14(5):564–567. doi: 10.1097/00007890-197211000-00006. [DOI] [PubMed] [Google Scholar]
- Huber P. R., Geyer E., Küng W., Matter A., Torhorst J., Eppenberger U. Retinoic acid-binding protein in human breast cancer and dysplasia. J Natl Cancer Inst. 1978 Dec;61(6):1375–1378. [PubMed] [Google Scholar]
- Jurin M., Tannock I. F. Influence of vitamin A on immunological response. Immunology. 1972 Sep;23(3):283–287. [PMC free article] [PubMed] [Google Scholar]
- Kung J. T., Brooks S. B., Jakway J. P., Leonard L. L., Talmage D. W. Suppression of in vitro cytotoxic response by macrophages due to induced arginase. J Exp Med. 1977 Sep 1;146(3):665–672. doi: 10.1084/jem.146.3.665. [DOI] [PMC free article] [PubMed] [Google Scholar]
- Levine L., Ohuchi K. Retinoids as well as tumour promoters enhance deacylation of cellular lipids and prostaglandin production in MDCK cells. Nature. 1978 Nov 16;276(5685):274–275. doi: 10.1038/276274a0. [DOI] [PubMed] [Google Scholar]
- Meltzer M. S., Cohen B. E. Tumor suppression by Mycobacterium bovis (strain BCG) enhanced by vitamin A. J Natl Cancer Inst. 1974 Aug;53(2):585–587. doi: 10.1093/jnci/53.2.585. [DOI] [PubMed] [Google Scholar]
- Polliack A., Sasson Z. B. Enhancing effect of excess topical vitamin A on Rous sarcomas in chickens. J Natl Cancer Inst. 1972 Feb;48(2):407–416. [PubMed] [Google Scholar]
- Rhodes J. Altered expression of human monocyte Fc receptors in malignant disease. Nature. 1977 Jan 20;265(5591):253–255. doi: 10.1038/265253a0. [DOI] [PubMed] [Google Scholar]
- Rhodes J., Bishop M., Benfield J. Tumor surveillance: how tumors may resist macrophage-mediated host defense. Science. 1979 Jan 12;203(4376):179–182. doi: 10.1126/science.758686. [DOI] [PubMed] [Google Scholar]
- Rhodes J. Macrophage heterogeneity in receptor activity: the activation of macrophage Fc receptor function in vivo and in vitro. J Immunol. 1975 Mar;114(3):976–981. [PubMed] [Google Scholar]
- Samuelsson B., Granström E., Green K., Hamberg M., Hammarström S. Prostaglandins. Annu Rev Biochem. 1975;44:669–695. doi: 10.1146/annurev.bi.44.070175.003321. [DOI] [PubMed] [Google Scholar]
- Schultz R. M., Pavlidis N. A., Stylos W. A., Chirigos M. A. Regulation of macrophage tumoricidal function: a role for prostaglandins of the E series. Science. 1978 Oct 20;202(4365):320–321. doi: 10.1126/science.694537. [DOI] [PubMed] [Google Scholar]
- Spitznagel J. K., Allison A. C. Mode of action of adjuvants: retinol and other lysosome-labilizing agents as adjuvants. J Immunol. 1970 Jan;104(1):119–127. [PubMed] [Google Scholar]
- Sporn M. B., Dunlop N. M., Newton D. L., Smith J. M. Prevention of chemical carcinogenesis by vitamin A and its synthetic analogs (retinoids). Fed Proc. 1976 May 1;35(6):1332–1338. [PubMed] [Google Scholar]
- Todaro G. J., De Larco J. E., Sporn M. B. Retinoids block phenotypic cell transformation produced by sarcoma growth factor. Nature. 1978 Nov 16;276(5685):272–274. doi: 10.1038/276272a0. [DOI] [PubMed] [Google Scholar]